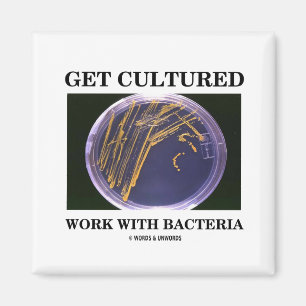
Aimant Obtenez le travail cultivé avec des bactéries (l

Cartes de visite juridique et finance
Cartes de visite marketing et com
Cartes de visite sport et fitness
Cartes de visite beauté et soins
Cartes de visite BTP et artisanat
Cartes de visite restauration
Cartes de visite photographie
Cartes de visite santé et bien-être
Aimant Soyez Nice aux bactéries
Prix8,10 €
Aimant Nous sommes des bactéries
Prix6,10 €
Magnet de bactéries pourpres
Prix5,40 €
Aimant Bac Bone Funny Bactteria Pun
Prix6,35 €
Aimant J'ai ton jeu de bactéries amusant
Prix6,35 €
Aimant Boogie avec des bactéries
Prix8,10 €
Aimant Germe idiot de bande dessinée
Prix6,10 €
Aimant Types De Bactéries
Prix6,10 €
Aimant Germe bleu de nuage
Prix6,10 €
Aimant Germe pourpre de bande dessinée
Prix6,10 €
Magnet Flexible Exobiologie
Prix6,65 €
Aimant propre/sale de boîte de Pétri de
Prix6,15 €
Aimant Covid-19
Prix6,50 €
Aimant Amis bactériens
Prix8,10 €
Aimant Microbes Virales
Prix6,10 €
Aimant Bac-atcha Funny Bacteria Pun
Prix6,35 €
Aimant Bactéries de Poo
Prix8,10 €
Aimant Vin Veritas - Cf d'en
Prix5,75 €
Aimant Amibes d'Adios
Prix8,10 €
Aimant Mal MRSA
Prix8,10 €
Aimant Tuberculose
Prix8,10 €
Aimant "Lait aigre"
Prix5,35 €
Aimant Le germe sont frais
Prix8,10 €
Aimant Streptocoque
Prix8,10 €
Aimant Ulcer
Prix8,10 €
Aimant Proverbe allemand - rétro
Prix5,75 €
Aimant Vin Veritas d'en - rétro
Prix5,75 €
Aimant Lave-toi les mains
Prix5,75 €
Aimant Vous ne pouvez pas B. Cereus
Prix5,70 €
Aimant Bactéries
Prix6,10 €
Aimant Fiole de culture
Prix8,10 €
Aimant Virus de grippe
Prix6,10 €
Aimant Germes
Prix6,10 €
Aimant Bactéries
Prix6,10 €
Aimant Germe rose
Prix6,10 €
La Promesse Zazzle
Garantie Coup de Coeur
Vous ne l'aimez pas ? Nous le reprenons ! 30 jours pour choisir, notre "Garantie 100% coup de cœur".
Livraison Internationale Simplifiée
Expédition sans soucis, sans frais cachés. Nous couvrons les frais de douane.
Achats Sécurisés Garantis
Paiement 100% sécurisé grâce au cryptage SSL.
Avis sur la recherche
Si vous avez besoin d'assistance ou si vous avez une question, consultez notre Aide